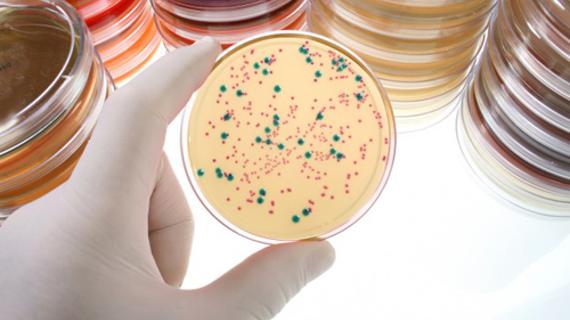

Медицинская практика Бактериальный вагиноз: новый взгляд на сложности терапии
В последние годы одним из ведущих мест в структуре акушерско-гинекологической заболеваемости нижнего отдела половых путей занимают инфекции влагалища, среди которых приоритет отдается бактериальному вагинозу. Бактериальный вагиноз — это проблема общемировая. Частота бактериального вагиноза варьирует, по данным различных авторов, от 30% до 60-80%.

6i44 
Портал «Фловит» 
6igx 


Портал «Заболевания Нет» 


Ортопед.ру 
Женский журнал «jlady» 

6i5z 


Клиника «EURODENT»

Портал «Фловит» 